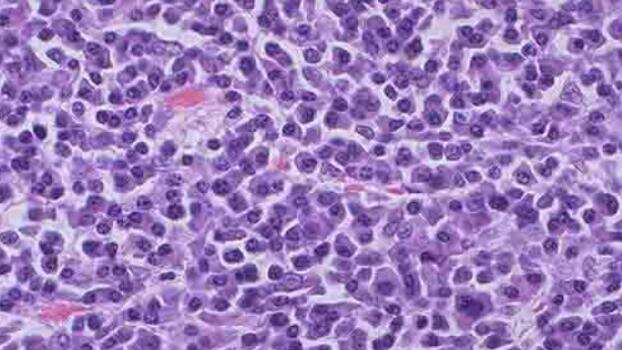
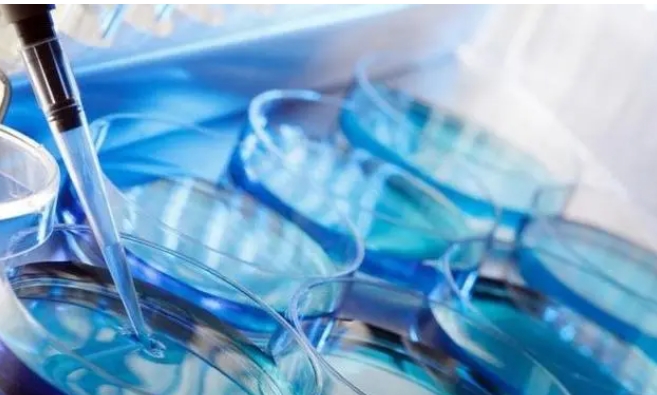

试管婴儿技术发展至今已有数十年,世界上首位试管婴儿今年已经40周岁了,尽管这项助孕技术已经不算年轻了,但是却仍然有很多人对它的认知存在偏差,前一段时间甚至有这样
内蒙古呼和浩特三代试管成功率比较高的医院是内蒙古自治区人民医院,其次是内蒙古医科大学附属第1医院,还有呼和浩特市妇幼保健院等。但具体哪家医院的成功率更高,需要根
随着医疗技术的不断发展,试管婴儿技术已经成为许多不孕不育患者的福音。泰国作为全球试管婴儿技术领跑的国家之一,拥有完善的医疗体系和先进的技术,吸引了众多来自世界各
女性生育是一件很幸福的事情,看着自己的小孩出生、成长、结婚。但随着现代人对于生活水平质量的提高、晚婚晚育、甚至不健康的生活规律导致不孕不育患者变多了,这也促使有
选择一家适合自己的试管婴儿医院是成功受孕的关键一步,那么如何才能从众多医院中找到比较合适的呢?下面将对长沙市几家知名的试管婴儿医院进行详细介绍,帮助大家更好地了
子宫内膜息肉在妇科疾病中属于很折磨人的疾病,这源于它的复发性。它会引起不规则阴道流血,还会引发不孕症。所以很多患者会问了,我患了子宫息肉,做试管婴儿能行吗?有没
南宁第三代试管比较好的医院包括:广西医科大学第1附属医院、广西壮族自治区人民医院、南宁市妇幼保健院、广西中医药大学附属瑞康医院、南宁市第1人民医院等。第三代试管
泰国作为全球领跑的试管婴儿目的地之一,每年吸引着来自世界各地的患者前往寻求名医在线助。那么2025年哪些试管医院脱颖而出,成为患者的优选呢?让我们一起来揭晓答案
大家在试管婴儿助孕治疗之前都会预先做一些功课,希望能够掌握一些关于试管婴儿的基本知识。在试管婴儿助孕的流程当中需要进行降调以及促排卵,目的是为了能够增加女性获卵
泰国三代试管婴儿的成功率受到多种因素的影响,例如年龄、卵巢储备、胚胎质量、子宫环境等。一般来说泰国三代试管婴儿的成功率在40%到60%之间,具体情况需要根据患者






